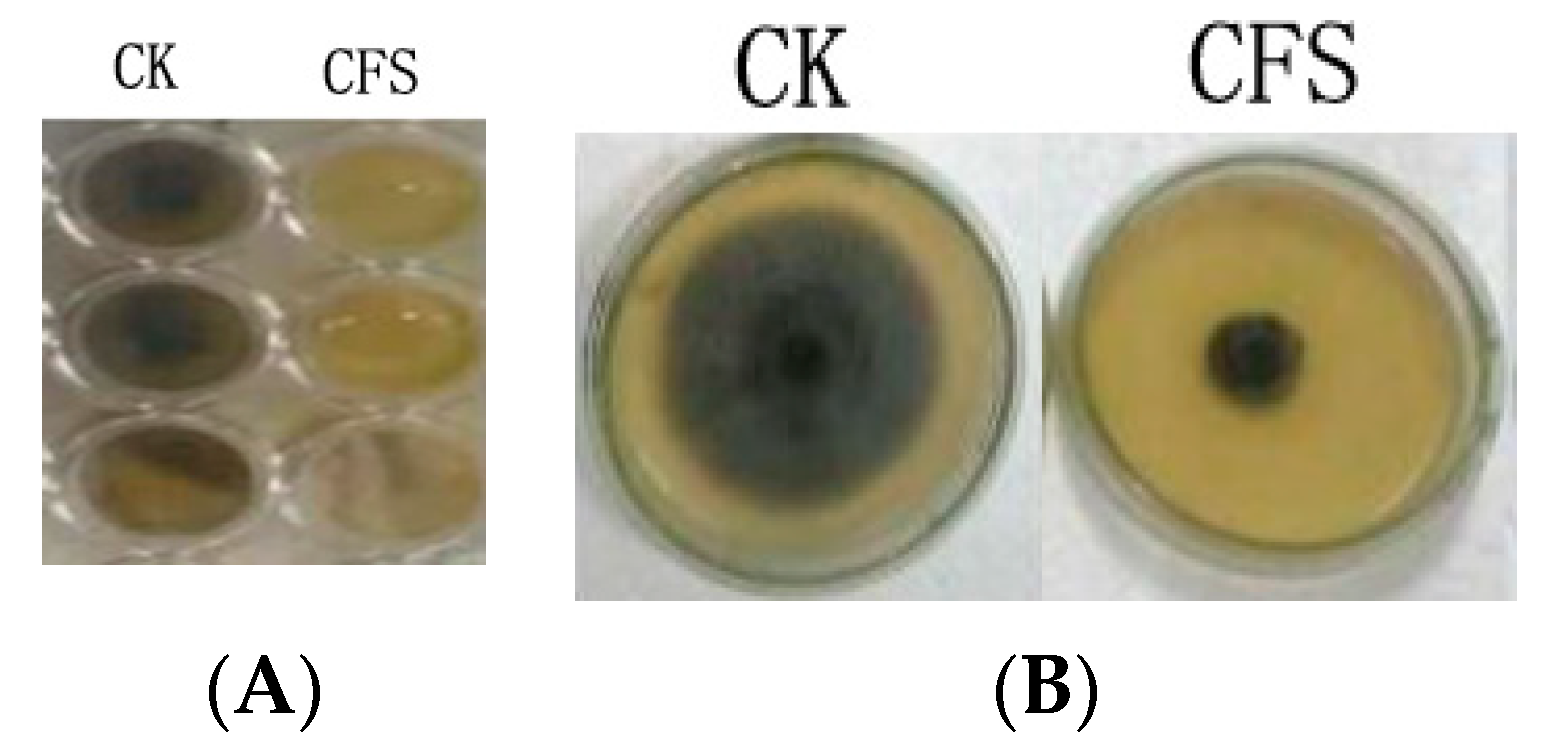
Horticulturae 09 00911 g001 Horticulturae 09 00911 g001

Antifungal Activity of Cell-Free Supernatants from Lactobacillus pentosus 86 against Alternaria gaisen
Abstract
1. Introduction
2. Materials and Methods
2.1. Strains and Culturing Conditions
2.2. Preparation of Cell-Free Supernatant Concentration (CFS)
2.3. Evaluate Antifungal Activity by 96-Well Plate Assay
2.4. Assessment of Mycelial Growth by Agar Dilution Method
2.5. Detection of Antimicrobial Stability
2.6. Spore Germination Assay
2.7. Measurement of Cellular Leakage
2.8. Morphology Observation
2.9. Measurement of Membrane Integrity
2.10. Statistical Analysis
3. Results
4. Discussion
5. Conclusions
Author Contributions
Funding
Data Availability Statement
Conflicts of Interest
References
- Nan, M.; Xue, H.; Bi, Y. Contamination, Detection and Control of Mycotoxins in Fruits and Vegetables. Toxins 2022, 14, 309. [Google Scholar] [CrossRef] [PubMed]
- Chen, Y.; Xing, M.; Chen, T.; Tian, S.; Li, B. Effects and Mechanisms of Plant Bioactive Compounds in Preventing Fungal Spoilage and Mycotoxin Contamination in Postharvest Fruits: A Review. Food Chem. 2023, 415, 135787. [Google Scholar] [CrossRef] [PubMed]
- Patriarca, A. Alternaria in Food Products. Curr. Opin. Food Sci. 2016, 11, 1–9. [Google Scholar] [CrossRef]
- Bacha, S.; Li, Y.; Nie, J.; Xu, G.; Han, L.; Farooq, S. Comprehensive Review on Patulin and Alternaria Toxins in Fruit and Derived Products. Front. Plant Sci. 2023, 14, 1139757. [Google Scholar] [CrossRef]
- Spadaro, D.; Droby, S. Development of Biocontrol Products for Postharvest Diseases of Fruit: The Importance of Elucidating the Mechanisms of Action of Yeast Antagonists. Trends Food Sci. Technol. 2016, 47, 39–49. [Google Scholar] [CrossRef]
- Dukare, A.S.; Paul, S.; Nambi, V.E.; Gupta, R.K.; Singh, R.; Sharma, K.; Vishwakarma, R.K. Exploitation of Microbial Antagonists for the Control of Postharvest Diseases of Fruits: A Review. Crit. Rev. Food Sci. Nutr. 2019, 59, 1498–1513. [Google Scholar] [CrossRef]
- Usall, J.; Torres, R.; Teixidó, N. Biological Control of Postharvest Diseases on Fruit: A Suitable Alternative? Curr. Opin. Food Sci. 2016, 11, 51–55. [Google Scholar] [CrossRef]
- Crowley, S.; Mahony, J.; van Sinderen, D. Current Perspectives on Antifungal Lactic Acid Bacteria as Natural Bio-Preservatives. Trends Food Sci. Technol. 2013, 33, 93–109. [Google Scholar] [CrossRef]
- Liu, A.; Xu, R.; Zhang, S.; Wang, Y.; Hu, B.; Ao, X.; Li, Q.; Li, J.; Hu, K.; Yang, Y.; et al. Antifungal Mechanisms and Application of Lactic Acid Bacteria in Bakery Products: A Review. Front. Microbiol. 2022, 13, 924398. [Google Scholar] [CrossRef]
- Mani-López, E.; Arrioja-Bretón, D.; López-Malo, A. The Impacts of Antimicrobial and Antifungal Activity of Cell-Free Supernatants from Lactic Acid Bacteria in Vitro and Foods. Compr. Rev. Food. Sci. Food Saf. 2022, 21, 604–641. [Google Scholar] [CrossRef]
- Ben Taheur, F.; Mansour, C.; Kouidhi, B.; Chaieb, K. Use of Lactic Acid Bacteria for the Inhibition of Aspergillus flavus and Aspergillus Carbonarius Growth and Mycotoxin Production. Toxicon 2019, 166, 15–23. [Google Scholar] [CrossRef]
- Li, M.; Xie, T.; Li, J.; Zhang, R. Identification of the Alternaria and Screening of the Lactic Acid Bacteria against Alternaria in South Xinjiang. Sci. Technol. Food Ind. 2017, 38, 145–150. [Google Scholar] [CrossRef]
- Ren, X.; Tuo, Y.; Liang, Y.; Li, N. Isolation, Identification and Detection of the Ability of Biofilm Formation of the Lactic Acid Bacteria Isolated from Yogurt and Yogurt Lump with Xinjiang Ethnic Characteristics. J. Tarim Univ. 2014, 26, 1–7. [Google Scholar]
- Iorizzo, M.; Ganassi, S.; Albanese, G.; Letizia, F.; Testa, B.; Tedino, C.; Petrarca, S.; Mutinelli, F.; Mazzeo, A.; De Cristofaro, A. Antimicrobial Activity from Putative Probiotic Lactic Acid Bacteria for the Biological Control of American and European Foulbrood Diseases. Vet. Sci. 2022, 9, 236. [Google Scholar] [CrossRef] [PubMed]
- Lee, H.; Lee, J.; Park, S.; Choi, I.; Lee, S. Antimicrobial Activity of Ligilactobacillus animalis Swla-1 and its Cell-Free Supernatant Against Multidrug-Resistant Bacteria and its Potential Use as an Alternative to Antimicrobial Agents. Microorganisms 2023, 11, 182. [Google Scholar] [CrossRef]
- Li, W.; Yuan, S.; Sun, J.; Li, Q.; Jiang, W.; Cao, J. Ethyl P-Coumarate Exerts Antifungal Activity in vitro and in vivo against Fruit Alternaria alternata via Membrane-Targeted Mechanism. Int. J. Food Microbiol. 2018, 278, 26–35. [Google Scholar] [CrossRef]
- Barman, S.; Ghosh, R.; Sengupta, S.; Mandal, N.C. Longterm Storage of Post-Packaged Bread by Controlling Spoilage Pathogens Using Lactobacillus fermentum C14 Isolated from Homemade Curd. PLoS ONE 2017, 12, e184020. [Google Scholar] [CrossRef]
- Wei, Y.; Wang, J.; Liu, Z.; Pei, J.; Brennan, C.; Abd El-Aty, A.M. Isolation and Characterization of Bacteriocin-Producing Lacticaseibacillus rhamnosus Xn2 from Yak Yoghurt and its Bacteriocin. Molecules 2022, 27, 2066. [Google Scholar] [CrossRef] [PubMed]
- Keeratikunakorn, K.; Kaewchomphunuch, T.; Kaeoket, K.; Ngamwongsatit, N. Antimicrobial Activity of Cell Free Supernatants from Probiotics Inhibits Against Pathogenic Bacteria Isolated from Fresh Boar Semen. Sci. Rep. 2023, 13, 5995. [Google Scholar] [CrossRef]
- Kaewchomphunuch, T.; Charoenpichitnunt, T.; Thongbaiyai, V.; Ngamwongsatit, N.; Kaeoket, K. Cell-Free Culture Supernatants of Lactobacillus spp. and Pediococcus spp. Inhibit Growth of Pathogenic Escherichia coli Isolated from Pigs in Thailand. BMC Vet. Res. 2022, 18, 60. [Google Scholar] [CrossRef] [PubMed]
- Shehata, M.G.; Badr, A.N.; El Sohaimy, S.A.; Asker, D.; Awad, T.S. Characterization of Antifungal Metabolites Produced by Novel Lactic Acid Bacterium and their Potential Application as Food Biopreservatives. Ann. Agric. Sci. 2019, 64, 71–78. [Google Scholar] [CrossRef]
- Yang, E.; Fan, L.; Yan, J.; Jiang, Y.; Doucette, C.; Fillmore, S.; Walker, B. Influence of Culture Media, pH and Temperature on Growth and Bacteriocin Production of Bacteriocinogenic Lactic Acid Bacteria. AMB Express 2018, 8, 10. [Google Scholar] [CrossRef] [PubMed]
- Prashant, K.; Jayachandran, K.; Suzana, S. Antimicrobial Peptides: Diversity, Mechanism of Action and Strategies to Improve the Activity and Biocompatibility In Vivo. Biomolecules 2018, 8, 4. [Google Scholar] [CrossRef]
- Girma, A.; Aemiro, A. Antibacterial Activity of Lactic Acid Bacteria Isolated from Fermented Ethiopian Traditional Dairy Products against Food Spoilage and Pathogenic Bacterial Strains. J. Food Qual. 2021, 2021, 9978561. [Google Scholar] [CrossRef]
- Reis, J.A.; Paula, A.T.; Casarotti, S.N.; Penna, A.L.B. Lactic Acid Bacteria Antimicrobial Compounds: Characteristics and Applications. Food Eng. Rev. 2012, 4, 124–140. [Google Scholar] [CrossRef]
- Zalán, Z.; Hudáček, J.; Štětina, J.; Chumchalová, J.; Halász, A. Production of Organic Acids by Lactobacillus Strains in Three Different Media. Eur. Food Res. Technol. 2010, 230, 395–404. [Google Scholar] [CrossRef]
- Huang, Y.; Shi, J.; Luo, S.; Xu, S.; Zhang, J.; Molnár, I.; Yang, Q.; Zhang, B. Antimicrobial Substances and Mechanisms of Lactobacillus rhamnosus against Gardnerella Vaginalis. Probiotics Antimicrob. Proteins 2023, 15, 400–410. [Google Scholar] [CrossRef]
- Sharaf, O.M.; Al-Gamal, M.S.; Ibrahim, G.A.; Dabiza, N.M.; Salem, S.S.; El-Ssayad, M.F.; Youssef, A.M. Evaluation and Characterization of Some Protective Culture Metabolites in Free and Nano-chitosan-loaded Forms Against Common Aontaminants of Egyptian Cheese. Carbohydr. Polym. 2019, 223, 115094. [Google Scholar] [CrossRef]
- Shu, X.; Wang, Y.; Zhou, Q.; Li, M.; Hu, H.; Ma, Y.; Chen, X.; Ni, J.; Zhao, W.; Huang, S.; et al. Biological Degradation of Aflatoxin B1 by Cell-Free Extracts of Bacillus velezensis Dy3108 with Broad Ph Stability and Excellent Thermostability. Toxins 2018, 10, 330. [Google Scholar] [CrossRef]
- Zhao, H.; Liu, K.; Fan, Y.; Cao, J.; Li, H.; Wu, S.; Liu, Y.; Miao, M. Cell-free supernatant of Bacillus velezensis Suppresses Mycelial Growth and Reduces Virulence of Botrytis cinerea by Inducing Oxidative stress. Front. Microbiol. 2022, 13, 2022. [Google Scholar] [CrossRef]
- Fan, J.; Ho, L.; Hobson, P.; Brookes, J. Evaluating the Effectiveness of Copper Sulphate, Chlorine, Potassium Permanganate, Hydrogen Peroxide and Ozone on Cyanobacterial Cell Integrity. Water Res. 2013, 47, 5153–5164. [Google Scholar] [CrossRef] [PubMed]
- Xu, W.; Wang, H.; Lv, Z.; Shi, Y.; Wang, Z. Antifungal Activity and Functional Components of Cell-Free Supernatant from Bacillus amyloliquefaciens Lzn01 Inhibit Fusarium oxysporum f. sp. niveum Growth. Biotechnol. Biotechnol. Equip. 2019, 33, 1042–1052. [Google Scholar] [CrossRef]
- He, J.; Jin, D.; Luo, X.; Zhang, T. Lhh1, a Novel Antimicrobial Peptide with Anti-Cancer Cell Activity Identified from Lactobacillus casei Hz1. AMB Express 2020, 10, 204. [Google Scholar] [CrossRef] [PubMed]
- Xu, C.; Fu, Y.; Liu, F.; Liu, Z.; Ma, J.; Jiang, R.; Song, C.; Jiang, Z.; Hou, J. Purification and Antimicrobial Mechanism of a Novel Bacteriocin Produced by Lactobacillus rhamnosus 1.0320. LWT 2021, 137, 110338. [Google Scholar] [CrossRef]
- Leon, R.; Ruiz, M.; Valero, Y.; Cardenas, C.; Guzman, F.; Vila, M. Exploring Small Cationic Peptides of Different Origin as Potential Antimicrobial Agents in Aquaculture. Fish Shellfish Immunol. 2020, 98, 720–727. [Google Scholar] [CrossRef]
- Guimares, A.; Venncio, A. The Potential of Fatty Acids and Their Derivatives as Antifungal Agents: A Review. Toxins 2022, 14, 188. [Google Scholar] [CrossRef]
- Jin, J.; Nguyen, T.T.H.; Humayun, S.; Park, S.; Oh, H.; Lim, S. Characteristics of Sourdough Bread Fermented with Pediococcus pentosaceus and Saccharomyces cerevisiae and Its Bio-preservative Effect against Aspergillus flavus. Food Chem. 2021, 345, 128787. [Google Scholar] [CrossRef]

| Thermal Treatments | Control Group (CK) | 40 °C | 60 °C | 80 °C | 100 °C |
| Antifungal activity (%) | 87.70 ± 0.47 a | 87.22 ± 0.49 a | 85.43 ± 1.67 b | 84.43 ± 2.11 b | 80.57 ± 2.03 c |
| Enzymatic treatments | Control group (CK) | Papain | Pepsin | Trypsin | Proteinase K |
| Antifungal activity (%) | 87.70 ± 0.47 ab | 86.20 ± 1.31 ab | 91.59 ± 2.17 a | 87.03 ± 1.16 ab | 82.60 ± 2.51 b |
| Acid treatments | pH 2 | pH 3 | pH 4 | pH 5 | pH 6 |
| Antifungal activity (%) | 93.30 ± 0.73 a | 90.97 ± 1.00 b | 85.73 ± 0.55 c | 21.03 ± 0.66 d | 0.00 ± 0.00 e |
Disclaimer/Publisher’s Note: The statements, opinions and data contained in all publications are solely those of the individual author(s) and contributor(s) and not of MDPI and/or the editor(s). MDPI and/or the editor(s) disclaim responsibility for any injury to people or property resulting from any ideas, methods, instructions or products referred to in the content. |
© 2023 by the authors. Licensee MDPI, Basel, Switzerland. This article is an open access article distributed under the terms and conditions of the Creative Commons Attribution (CC BY) license (https://creativecommons.org/licenses/by/4.0/).
Share and Cite
Liu, H.; Zhang, R.; Zhang, Q.; Tian, M.; Ren, X.; Wang, L.; Wang, X. Antifungal Activity of Cell-Free Supernatants from Lactobacillus pentosus 86 against Alternaria gaisen. Horticulturae 2023, 9, 911. https://doi.org/10.3390/horticulturae9080911
Liu H, Zhang R, Zhang Q, Tian M, Ren X, Wang L, Wang X. Antifungal Activity of Cell-Free Supernatants from Lactobacillus pentosus 86 against Alternaria gaisen. Horticulturae. 2023; 9(8):911. https://doi.org/10.3390/horticulturae9080911
Chicago/Turabian StyleLiu, Huaying, Ruili Zhang, Qiuqin Zhang, Mengtian Tian, Xiaopu Ren, Libin Wang, and Xiaohong Wang. 2023. "Antifungal Activity of Cell-Free Supernatants from Lactobacillus pentosus 86 against Alternaria gaisen" Horticulturae 9, no. 8: 911. https://doi.org/10.3390/horticulturae9080911
APA StyleLiu, H., Zhang, R., Zhang, Q., Tian, M., Ren, X., Wang, L., & Wang, X. (2023). Antifungal Activity of Cell-Free Supernatants from Lactobacillus pentosus 86 against Alternaria gaisen. Horticulturae, 9(8), 911. https://doi.org/10.3390/horticulturae9080911

